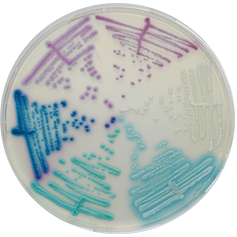

Productcode: CA243-25
Supplier: CHROMagar
Package size: 25000 ml
CHROMagar™ Candida Plus is the first chromogenic isolation medium to detect and differentiate C. auris in addition to other major clinical Candida species such as C. albicans, C. tropicalis, C. glabrata or C. krusei.
The Candida are yeasts involved in various infections called Candidiasis, which can affect damaged skin, respiratory tract, digestive and urogenital systems. These Candidiasis can be severe with significant morbidity for nosocomial infections or in immunocompromised patients. Although C. albicans is still the main species involved, the use of anti fungal agents has even rise to other species such as C. tropicalis, C. krusei and C. glabrata.
For more information from Labema’s specialist. The specialist for this product is Toni Sofronjuk.